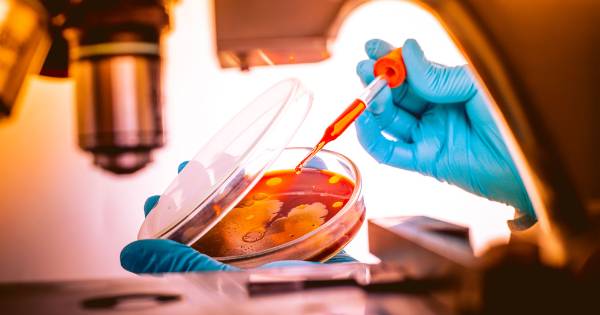
image for Public Health, MPH

East Tennessee State University offers online and mostly online programs. Some programs include field work experiences, please check the program's page for specific requirements. Mostly online programs offer a majority of the required coursework online with limited on-campus coursework or meetings required.
Online Programs
Mostly Online Programs
OnlineMastersColleges.com named ETSU among the top institutions for online master’s programs in Tennessee, citing the university’s reputation for academic excellence and a wide range of graduate-level programs in fields such as health care, education and business.

To see ETSU's full on-campus programs list, visit the graduate school website.
 Possible Outlook Issues
Possible Outlook Issues  Stout Drive Road Closure
Stout Drive Road Closure